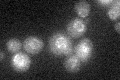
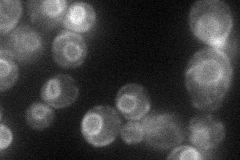
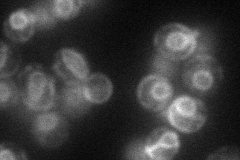

View description
Essential nuclear envelope integral membrane protein identified as a suppressor of a conditional mutation in the major karyopherin, CRM1; homologous to and interacts with Brr6p, a nuclear envelope protein involved in nuclear export
Localization:
Intensity:
Fold change:
Significance:
-
C’ GFP library in SD
ER24.06 -
N' NOP1pr-GFP in SD
ER45.7394 -
N' TEF2pr-mCherry in SD
ER50.4281 -
N' NATIVEpr-GFP in SD

ER,punctate21.6596 -
N' TEF2pr-VC and Cyto-VN in SD

ER33.9827 -
C’ GFP library in SD+DTT

ER20.370.84No -
C’ GFP library in SD+H2O2

ER21.980.91No -
C’ GFP library in Starvation Media

ER15.560.64Yes -
C’ GFP library on the background of Pup2-DaMP

ER -
C’ GFP library on the background of CCT mutant

ER22.88050.95078No
